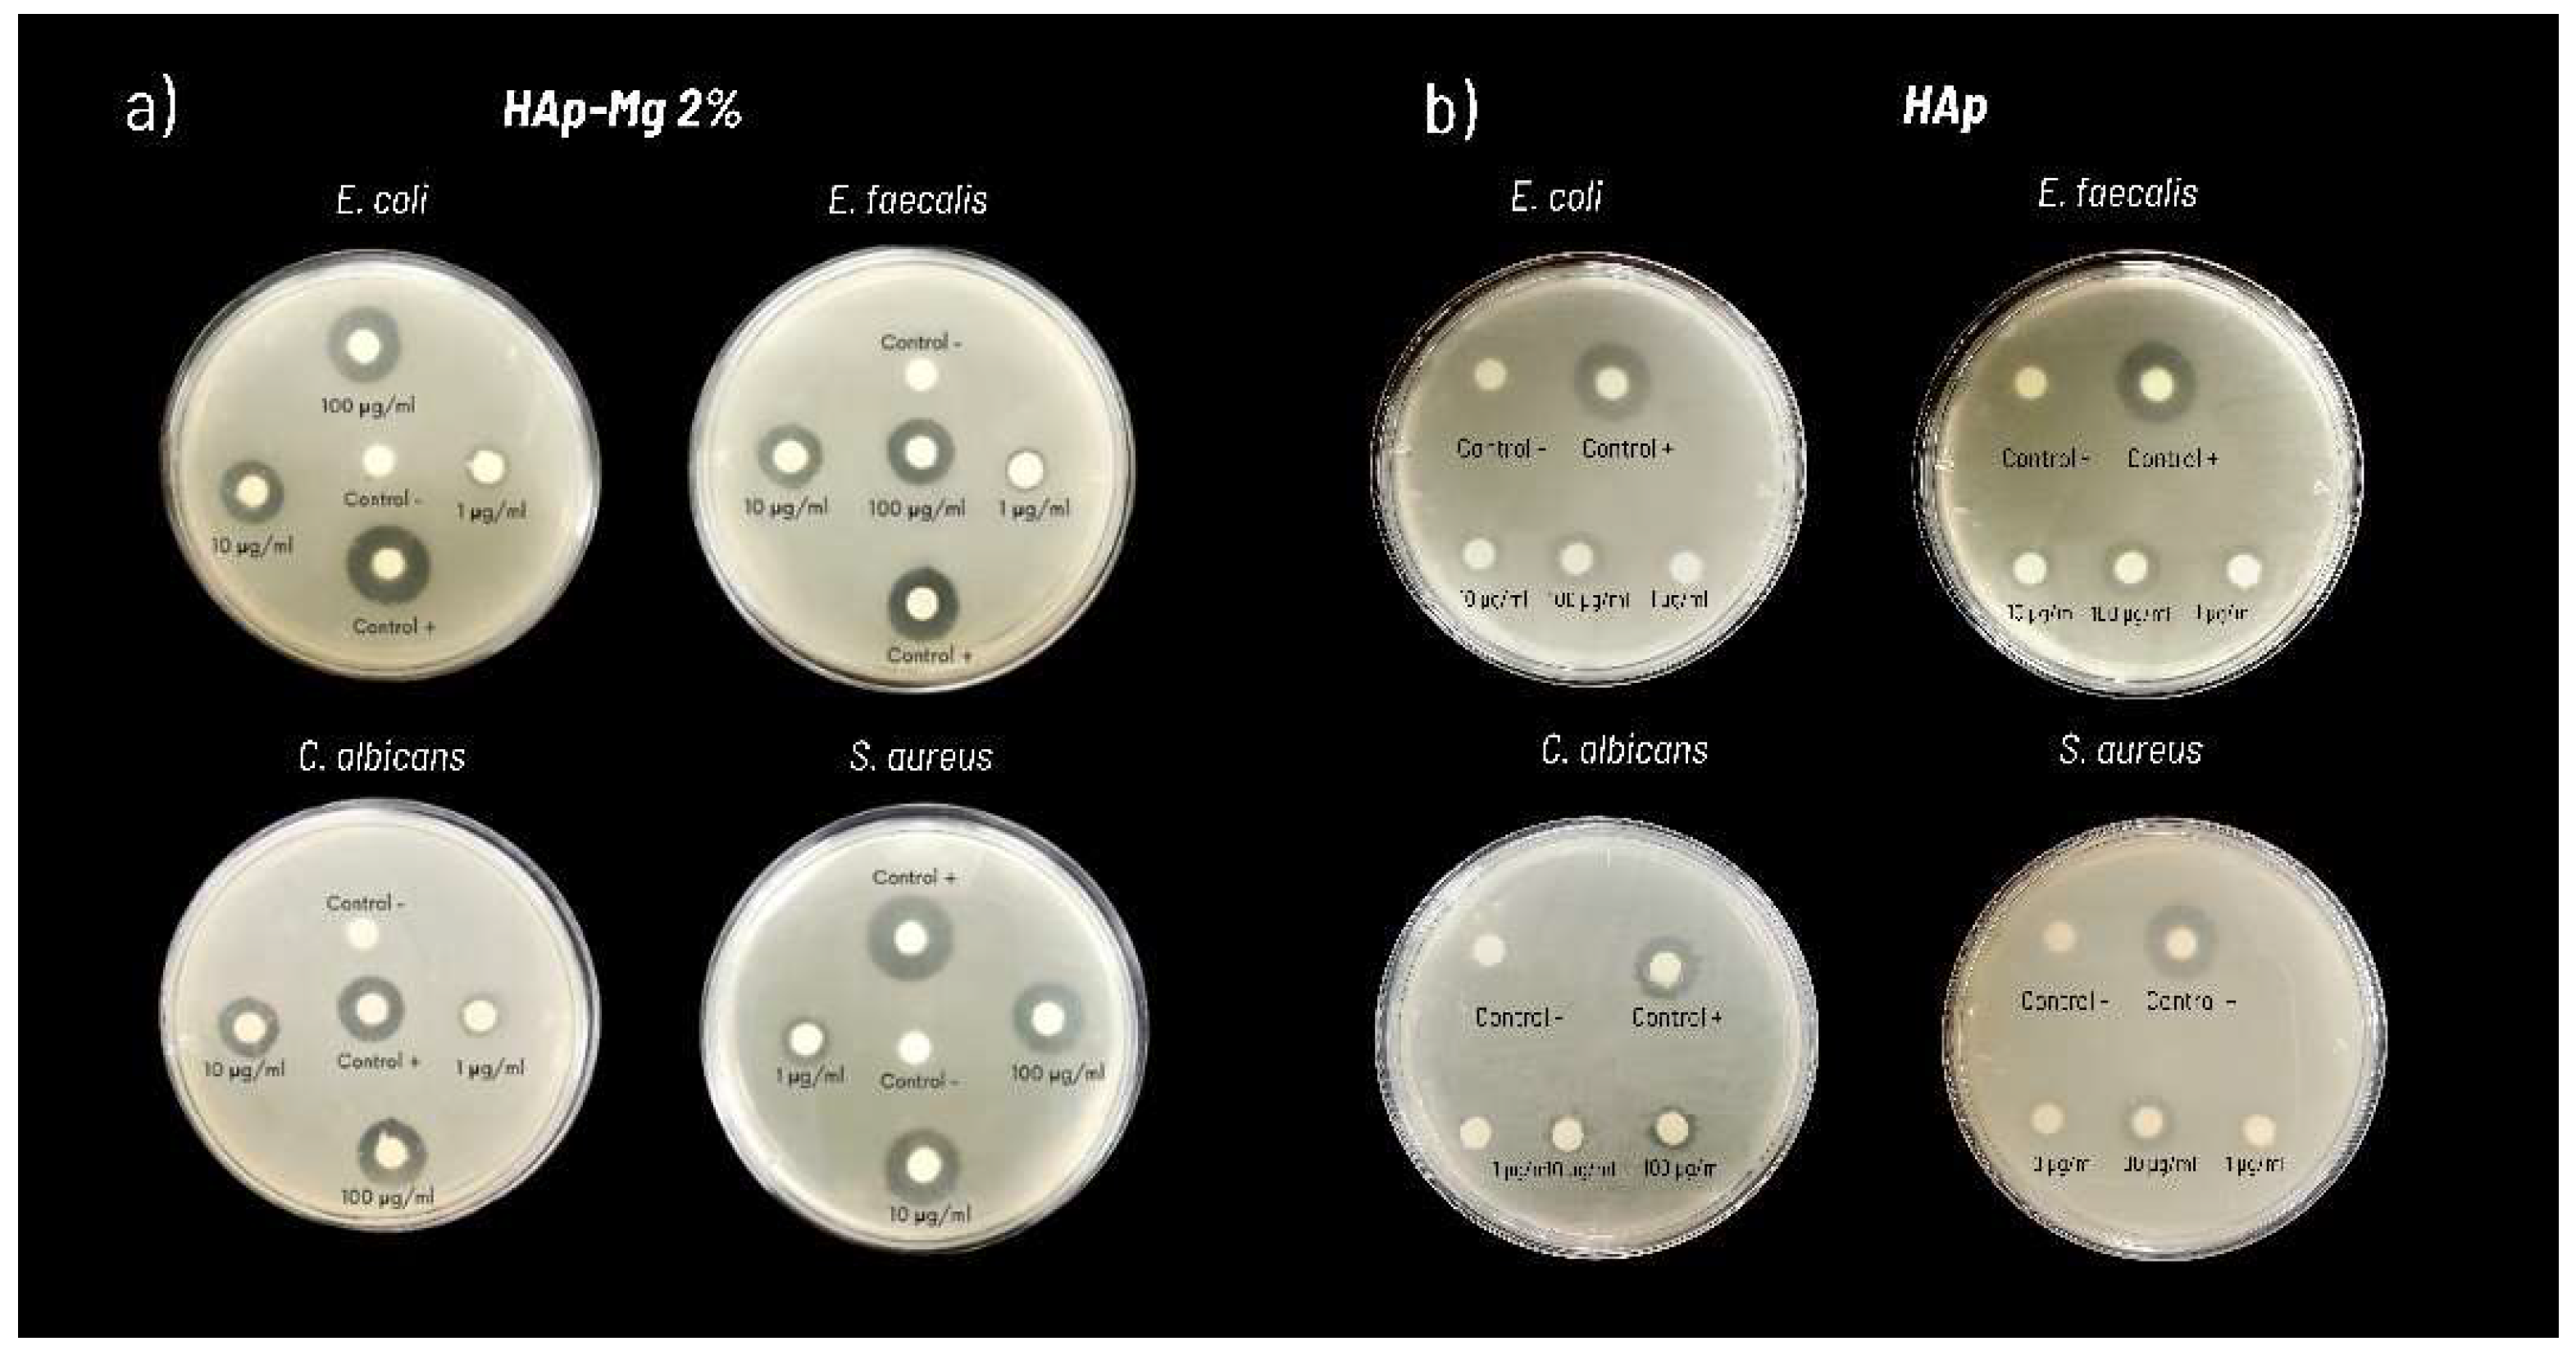

Submitted:
09 October 2024
Posted:
10 October 2024
You are already at the latest version
Abstract

Keywords:
Graphical Abstract

1. Introduction
2. Results
2.1. Characterization of HAp-Mg Nanofibers
2.1.1. Scanning Electron Microscopy
2.1.2. X-ray Diffraction
2.1.3. Transmission Electron Microscopy
2.1.3. Attenuated Total Reflection-Fourier Transform Infrared Spectroscopy (ATR-FTIR)
2.1.4. Energy-Dispersive X-Ray Spectroscopy Analysis
2.2. Biocompatibility, Cell Viability and Cytotoxicity In Vitro Assays
2.3. Evaluation of the Antimicrobial activity of HAp Pure and HAp-Mg
3. Discussion
4. Materials and Methods
4.1. Synthesis of HAp-Mg Using Microwave-Assisted Hydrothermal Method
4.2. Characterization of Nanomaterial
4.2.1. X-Ray Diffraction
4.2.2. Scanning Electron Microscopy
4.2.3. Transmission Electron Microscopy
4.2.4. Energy-Dispersive X-Ray Spectroscopy Analysis
4.2.5. FTIR-ATR
4.3. Biocompatibility, Cell Viability and Cytotoxicity In Vitro Experiments
4.3.1. Experimental Animals
4.3.2. Fibroblast Cell Cultures and Treatments with HAp-Mg
4.3.3. Cell Survival and Cytotoxicity Assay
4.3.4. Antimicrobial Activity Evaluation of HAp-Mg
4.3.5. Statistical Analysis
5. Conclusions
Author Contributions
Funding
Institutional Review Board Statement
Informed Consent Statement
Acknowledgments
Conflicts of Interest
References
- Bal, Z.; Kaito, T.; Korkusuz, F.; Yoshikawa, H. Bone Regeneration with Hydroxyapatite-Based Biomaterials. Emergent Mater 2020, 3, 521–544. [Google Scholar] [CrossRef]
- Kazimierczak, P.; Przekora, A. Osteoconductive and Osteoinductive Surface Modifications of Biomaterials for Bone Regeneration: A Concise Review. Coatings 2020, 10, 1–25. [Google Scholar] [CrossRef]
- Samadikuchaksaraei, A.; Gholipourmalekabadi, M.; Erfani Ezadyar, E.; Azami, M.; Mozafari, M.; Johari, B.; Kargozar, S.; Jameie, S.; Korourian, A.; Seifalian, A. Fabrication and in Vivo Evaluation of an Osteoblast-Conditioned Nano-Hydroxyapatite/Gelatin Composite Scaffold for Bone Tissue Regeneration. J Biomed Mater Res A 2016, 104, 2001–2010. [Google Scholar] [CrossRef] [PubMed]
- Hu, Y.; Chen, J.; Fan, T.; Zhang, Y.; Zhao, Y.; Shi, X.; Zhang, Q. Biomimetic Mineralized Hierarchical Hybrid Scaffolds Based on in Situ Synthesis of Nano-Hydroxyapatite/Chitosan/Chondroitin Sulfate/Hyaluronic Acid for Bone Tissue Engineering. Colloids Surf B Biointerfaces 2017, 157, 93–100. [Google Scholar] [CrossRef] [PubMed]
- Bal, Z.; Kaito, T.; Korkusuz, F.; Yoshikawa, H. Bone Regeneration with Hydroxyapatite-Based Biomaterials. Emergent Mater 2020, 3, 521–544. [Google Scholar] [CrossRef]
- Jing, Z.; Cao, Q.; Jun, H. Corrosion, Wear and Biocompatibility of Hydroxyapatite Bio-Functionally Graded Coating on Titanium Alloy Surface Prepared by Laser Cladding. Ceram Int 2021, 47, 24641–24651. [Google Scholar] [CrossRef]
- Wang, L.; Xu, L.; Peng, C.; Teng, G.; Wang, Y.; Xie, X.; Wu, D. The Effect of Bone Marrow Mesenchymal Stem Cell and Nano hydroxyapatite/Collagen I/Poly L lactic Acid Scaffold Implantation on the Treatment of Avascular Necrosis of the Femoral Head in Rabbits. Exp Ther Med 2019. [Google Scholar] [CrossRef]
- Lu, J.; Yu, H.; Chen, C. Biological Properties of Calcium Phosphate Biomaterials for Bone Repair: A Review. RSC Adv 2018, 8, 2015–2033. [Google Scholar] [CrossRef]
- Lin, L.; Chow, K.L.; Leng, Y. Study of Hydroxyapatite Osteoinductivity with an Osteogenic Differentiation of Mesenchymal Stem Cells. J Biomed Mater Res A 2009, 89, 326–335. [Google Scholar] [CrossRef]
- Prado, J.P.d.S.; Yamamura, H.; Magri, A.M.P.; Ruiz, P.L.M.; Prado, J.L. dos S.; Rennó, A.C.M.; Ribeiro, D.A.; Granito, R.N. In Vitro and in Vivo Biological Performance of Hydroxyapatite from Fish Waste. J Mater Sci Mater Med 2021, 32. [Google Scholar] [CrossRef]
- Zhao, X.; Yang, Z.; Liu, Q.; Yang, P.; Wang, P.; Wei, S.; Liu, A.; Zhao, Z. Potential Load-Bearing Bone Substitution Material: Carbon-Fiber-Reinforced Magnesium-Doped Hydroxyapatite Composites with Excellent Mechanical Performance and Tailored Biological Properties. CS Biomater. Sci. Eng. 2022, 8, 921–938. [Google Scholar] [CrossRef] [PubMed]
- Chen, Z.; Zhang, W.; Wang, M.; Backman, L.; Chen, J. Effects of Zinc, Magnesium, and Iron Ions on Bone Tissue Engineering. ACS Biomater. Sci. Eng. 2022, 8, 2321–2335. [Google Scholar] [CrossRef] [PubMed]
- Iconaru, S.L.; Ciobanu, C.S.; Predoi, G.; Rokosz, K.; Chifiriuc, M.C.; Bleotu, C.; Stanciu, G.; Hristu, R.; Raaen, S.; Raita, S.M.; et al. Biological and Physico-Chemical Properties of Composite Layers Based on Magnesium-Doped Hydroxyapatite in Chitosan Matrix. Micromachines (Basel) 2022, 13. [Google Scholar] [CrossRef] [PubMed]
- Predoi, D.; Ciobanu, C.S.; Iconaru, S.L.; Raaen, S.; Badea, M.L.; Rokosz, K. Physicochemical and Biological Evaluation of Chitosan-Coated Magnesium-Doped Hydroxyapatite Composite Layers Obtained by Vacuum Deposition. Coatings 2022, 12. [Google Scholar] [CrossRef]
- Predoi, D.; Iconaru, S.L.; Predoi, M.V.; Stan, G.E.; Buton, N. Synthesis, Characterization, and Antimicrobial Activity of Magnesium-Doped Hydroxyapatite Suspensions. Nanomaterials 2019, 9. [Google Scholar] [CrossRef] [PubMed]
- Iconaru, S.L.; Predoi, M.V.; Motelica-Heino, M.; Predoi, D.; Buton, N.; Megier, C.; Stan, G.E. Dextran-Thyme Magnesium-Doped Hydroxyapatite Composite Antimicrobial Coatings. Coatings 2020, 10. [Google Scholar] [CrossRef]
- Kumar, G.S.; Karunakaran, G.; Girija, E.K.; Kolesnikov, E.; Minh, N. Van; Gorshenkov, M. V.; Kuznetsov, D. Size and Morphology-Controlled Synthesis of Mesoporous Hydroxyapatite Nanocrystals by Microwave-Assisted Hydrothermal Method. Ceram Int 2018, 44, 11257–11264. [Google Scholar] [CrossRef]
- Alanís-Gómez, J.R.; Rivera-Muñoz, E.M.; Peza-Ledesma, C.; Manzano-Ramírez, A.; Velázquez-Castillo, R. A Comparison of Mechanical Properties of Different Hydroxyapatite (HAp) Based Nanocomposites: The Influence of Morphology and Preferential Orientation. J Nanosci Nanotechnol 2019, 20, 1968–1976. [Google Scholar] [CrossRef]
- Alanís-Gómez, J.R.; Rivera-Muñoz, E.M.; Cervantes-Medina, J.S.; Almanza-Reyes, H.; Nava-Mendoza, R.; Cortes-Romero, C.; Velázquez-Castillo, R. Synthesis of Micro and Nano-Sized Hydroxyapatite Fibers through the Microwave Assisted Hydrothermal Method. J Nanosci Nanotechnol 2016, 16, 7557–7566. [Google Scholar] [CrossRef]
- Alanís-Gómez, J.R.; Rivera-Muñoz, E.M.; Cervantes-Medina, J.S.; Almanza-Reyes, H.; Nava-Mendoza, R.; Cortes-Romero, C.; Velázquez-Castillo, R. Synthesis of Micro and Nano-Sized Hydroxyapatite Fibers through the Microwave Assisted Hydrothermal Method. J Nanosci Nanotechnol 2016, 16, 7557–7566. [Google Scholar] [CrossRef]
- Zhou, H.; Luchini, T.J.F.; Bhaduri, S.B. Microwave Assisted Synthesis of Amorphous Magnesium Phosphate Nanospheres. J Mater Sci Mater Med 2012, 23, 2831–2837. [Google Scholar] [CrossRef] [PubMed]
- Nabiyouni, M.; Brückner, T.; Zhou, H.; Gbureck, U.; Bhaduri, S.B. Magnesium-Based Bioceramics in Orthopedic Applications. Acta Biomater 2018, 66, 23–43. [Google Scholar] [PubMed]
- Zhao, S.; Jiang, Q.; Peel, S.; Wang, X.; He, F. Effects of Magnesium-Substituted Nanohydroxyapatite Coating on Implant Osseointegration. Clin Oral Implants Res 2013, 24, 34–41. [Google Scholar] [CrossRef] [PubMed]
- Zhou, H.; Liang, B.; Jiang, H.; Deng, Z.; Yu, K. Magnesium-Based Biomaterials as Emerging Agents for Bone Repair and Regeneration: From Mechanism to Application. Journal of Magnesium and Alloys 2021, 9, 779–804. [Google Scholar]
- Iconaru, S.L.; Predoi, M.V.; Motelica-Heino, M.; Predoi, D.; Buton, N.; Megier, C.; Stan, G.E. Dextran-Thyme Magnesium-Doped Hydroxyapatite Composite Antimicrobial Coatings. Coatings 2020, 10. [Google Scholar] [CrossRef]
- Predoi, D.; Iconaru, S.L.; Predoi, M.V.; Motelica-Heino, M.; Buton, N.; Megier, C. Obtaining and Characterizing Thin Layers of Magnesium Doped Hydroxyapatite by Dip Coating Procedure. Coatings 2020, 510. [Google Scholar] [CrossRef]
- Predoi, D.; Iconaru, S.L.; Predoi, M.V.; Stan, G.E.; Buton, N. Synthesis, Characterization, and Antimicrobial Activity of Magnesium-Doped Hydroxyapatite Suspensions. Nanomaterials 2019, 9. [Google Scholar] [CrossRef]
- Predoi, D.; Ciobanu, S.C.; Iconaru, S.L.; Predoi, M.V. Influence of the Biological Medium on the Properties of Magnesium Doped Hydroxyapatite Composite Coatings. Coatings 2023, 13. [Google Scholar] [CrossRef]
- Hamid, R.; Rotshteyn, Y.; Rabadi, L.; Parikh, R.; Bullock, P. Comparison of Alamar Blue and MTT Assays for High Through-Put Screening. Toxicology in Vitro 2004, 18, 703–710. [Google Scholar] [CrossRef]
- Kumar, P.; Nagarajan, A.; Uchil, P.D. Analysis of Cell Viability by the Alamarblue Assay. Cold Spring Harb Protoc 2018, 2018, 462–464. [Google Scholar] [CrossRef]
- He, L.Y.; Zhang, X.M.; Liu, B.; Tian, Y.; Ma, W.H. Effect of Magnesium Ion on Human Osteoblast Activity. Brazilian Journal of Medical and Biological Research 2016, 49. [Google Scholar] [CrossRef] [PubMed]
- Maier, J.; Kretsinger, R.; Uversky, V.; Permyakov, E. Magnesium and Cell Cycle; Springer New York, 2013.
- Belluci, M.M.; Schoenmaker, T.; Rossa-Junior, C.; Orrico, S.R.; de Vries, T.J.; Everts, V. Magnesium Deficiency Results in an Increased Formation of Osteoclasts. Journal of Nutritional Biochemistry 2013, 24, 1488–1498. [Google Scholar] [CrossRef] [PubMed]
- Rude, R.K.; Wei, L.; James Norton, H.; Lu, S.S.; Dempster, D.W.; Gruber, H.E. TNFα Receptor Knockout in Mice Reduces Adverse Effects of Magnesium Deficiency on Bone. Growth Factors 2009, 27, 370–376. [Google Scholar] [CrossRef] [PubMed]
- Nguyen, N.Y.T.; Grelling, N.; Wetteland, C.L.; Rosario, R.; Liu, H. Antimicrobial Activities and Mechanisms of Magnesium Oxide Nanoparticles (NMgO) against Pathogenic Bacteria, Yeasts, and Biofilms. Sci Rep 2018, 8. [Google Scholar] [CrossRef]
- Demishtein, K.; Reifen, R.; Shemesh, M. Antimicrobial Properties of Magnesium Open Opportunities to Develop Healthier Food. Nutrients 2019, 11. [Google Scholar] [CrossRef]
- Nagaraj, S.; Manivannan, S.; Narayan, S. Potent Antifungal Agents and Use of Nanocarriers to Improve Delivery to the Infected Site: A Systematic Review. J Basic Microbiol 2021, 61, 849–873. [Google Scholar] [CrossRef]
- Tornero-Gutiérrez, F.; Ortiz-Ramírez, J.A.; López-Romero, E.; Cuéllar-Cruz, M. Materials Used to Prevent Adhesion, Growth, and Biofilm Formation of Candida Species. Med Mycol 2023, 61. [Google Scholar] [CrossRef]

| Parameter/Sample | HAp (nm) | HAp-Mg 2% (nm) | HAp-Mg 5% (nm) |
|---|---|---|---|
| a | 0.942907 ± 1.8 x105 | 0.941681 ± 8.6 x105 | 0.94146 ± 1.1 x105 |
| c | 0.688033 ± 4 x105 | 0.687138 ± 6.8 x105 | 0.685711 ± 8.5 x105 |
| Crystallite size | 96 ± 1.8 | 55.3 ± 2.6 | 39.3 ± 1.6 |
| No. | Mode | HAp comercial | HAp-Mg 2% | HAp pure |
|---|---|---|---|---|
| 1 | P-O | - | - | 411 |
| 2 | PO₄³⁻ | 559 | 559 | 559 |
| 3 | PO₄³⁻ | 596 | 599 | 599 |
| 4 | –OH | 635 | - | 635 |
| 5 | M-O | - | 536 | - |
| 6 | PO₄³⁻ | 960 | - | 962 |
| 7 | PO₄³⁻ | 1018 | 1021 | 1021 |
| 8 | PO₄³⁻ | 1098 | - | 1101 |
| HAp commercial | HAp pure | HAp-Mg 2% | HAp- Mg 5% | |||||
|---|---|---|---|---|---|---|---|---|
| Element | Weight% | Atom% | Weight% | Atom% | Weight% | Atom% | Weight% | Atom% |
| Carbon | 6.061191 | 10.76036 | 5.18961 | 11.78154 | 1.925941 | 4.87836 | 7.076409 | 12.13933 |
| Oxygen | 45.95892 | 61.26107 | 39.98652 | 51.36676 | 13.29494 | 25.28091 | 48.95192 | 63.04156 |
| Magnesium | - | - | - | - | 0.114115 | 0.142843 | 0.491616 | 0.416765 |
| Phosphorus | 15.55336 | 10.71023 | 18.41139 | 17.66165 | 25.85541 | 25.39612 | 13.40304 | 8.916002 |
| Calcium | 32.45608 | 17.27032 | 41.79752 | 29.63575 | 55.5954 | 42.20295 | 29.98288 | 15.41446 |
| Ca/P ratio | - | 1.61251 | - | 1.6779 | - | 1.66179 | - | 1.72885 |
| HAp-Mg 2% Inhibition diameter (mm) | |||||||||
|---|---|---|---|---|---|---|---|---|---|
| Strain | Positive control | Standard error | Negative control* | HAp-Mg 2% 100 µg/mL |
Standard error | HAp-Mg 2% 10 µg/mL |
Standard error | HAp-Mg 2% 1 µg/mL |
Standard error |
| Escherichia coli | 21.0 | 0.8 | *- | 15 .0 | 0.9 | 12.0 | 0.7 | 10.3 | 1.1 |
| Enterococcus faecalis | 20.5 | 0.7 | *- | 13.5 | 0.9 | 11.0 | 0.6 | 9.5 | 0.7 |
| Staphylococcus aureus | 22.0 | 1.1 | *- | 14.0 | 0.4 | 9.0 | 0.9 | 5.0 | 0.6 |
| Candida albicans | 17.0 | 0.4 | *- | 8.5 | 0.6 | 5.5 | 0.3 | 3.5 | 0.5 |
| HAp Inhibition diameter (mm) | |||||||||
| Strain | Positive control | Standard error | Negative control* | HAp pure 100 µg/mL |
Standard error | HAp pure 10 µg/mL |
Standard error | HAp pure 1 µg/mL |
Standard error |
| Escherichia coli | 22.5 | 1.0 | *- | 8.5 | 1.0 | 7.0 | 1.2 | *- | - |
| Enterococcus faecalis | 20.0 | 1.2 | *- | 10.0 | 1.2 | 7.5 | 1.0 | *- | - |
| Staphylococcus aureus | 21.5 | 0.9 | *- | 7.2 | 0.9 | 6.0 | 1.5 | *- | - |
| Candida albicans | 19.0 | 1.3 | *- | 6.3 | 1.3 | *- | - | *- | - |
Disclaimer/Publisher’s Note: The statements, opinions and data contained in all publications are solely those of the individual author(s) and contributor(s) and not of MDPI and/or the editor(s). MDPI and/or the editor(s) disclaim responsibility for any injury to people or property resulting from any ideas, methods, instructions or products referred to in the content. |
© 2024 by the authors. Licensee MDPI, Basel, Switzerland. This article is an open access article distributed under the terms and conditions of the Creative Commons Attribution (CC BY) license (http://creativecommons.org/licenses/by/4.0/).